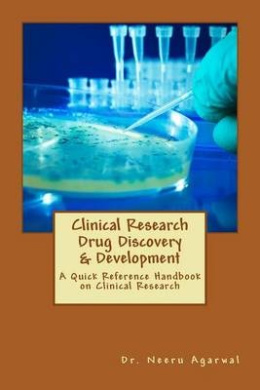
https://raw.githubusercontent.com/stevesteve2020-lab/img/refs/heads/main/QnBgvMTxaVhGI5.jpeg

-
-83%
Clinical Research Drug Discovery & Development: A Quick Reference Handbook on Clinical Research
0Original price was: $100.00.$17.00Current price is: $17.00.Clinical Research Drug Discovery & Development: A Quick Reference Handbook on Clinical Research, Davidian, Marie, 9781505586886
-
-88%

Clinical Research in Drug Discovery & Development
0Original price was: $116.00.$14.00Current price is: $14.00.Clinical Research in Drug Discovery & Development, Himanshu Basrani, 9781518836442
-
-90%

Clinical Research: Principles and Practise
0Original price was: $114.00.$11.00Current price is: $11.00.Clinical Research: Principles and Practise, Line L. Villadsen, 9781517137212
-
-76%

Common Terms in Cardiac Surgery
0Original price was: $45.00.$11.00Current price is: $11.00.Common Terms in Cardiac Surgery, Paul A. Iaizzo, 9781985156098
-
-81%

Computational Drug Discovery: Drug Discovery Process & Methods
0Original price was: $36.00.$7.00Current price is: $7.00.Computational Drug Discovery: Drug Discovery Process & Methods, Line L. Villadsen, 9781517184858
-
-83%

Cosmetic Surgery – Do I Really Need It? – A Guide to Plastic Surgery
0Original price was: $96.00.$16.00Current price is: $16.00.Cosmetic Surgery – Do I Really Need It? – A Guide to Plastic Surgery, David S. Younger, 9781517072100
-
-70%

Cranial Anatomy & Surgical Approaches: A Study Guide – Parts I & II
0Original price was: $60.00.$18.00Current price is: $18.00.Cranial Anatomy & Surgical Approaches: A Study Guide – Parts I & II, Dr Daniel J Rosenthal, 9781975680978
-
-88%

Cst Study Guide: Plus Over 1000 Questions and Answers
0Original price was: $60.00.$7.00Current price is: $7.00.Cst Study Guide: Plus Over 1000 Questions and Answers, David S. Younger, 9781541300583
-
-83%

Dallo Spiritualismo allo Spiritismo: Gli scopi della fatica medianica, veicolo dell’attivit spirituale.
0Original price was: $42.00.$7.00Current price is: $7.00.Dallo Spiritualismo allo Spiritismo: Gli scopi della fatica medianica, veicolo dell’attivit spirituale., Md. Sahab Uddin, 9781523488735
-
-91%

Dangleben’s Random SUrgery Review: ABSITE & Surgical Clerkship
0Original price was: $116.00.$11.00Current price is: $11.00.Dangleben’s Random SUrgery Review: ABSITE & Surgical Clerkship, Paul A. Iaizzo, 9781986765213
-
-84%

Diseccion del Cuello En El Cancer Oral
0Original price was: $57.00.$9.00Current price is: $9.00.Diseccion del Cuello En El Cancer Oral, Rose Ballard, 9781537623986
-
-82%

Drug Safety: Pharmacovigilance & Pharmacoepidemiology & Database
0Original price was: $68.00.$12.00Current price is: $12.00.Drug Safety: Pharmacovigilance & Pharmacoepidemiology & Database, Line L. Villadsen, 9781511686785


